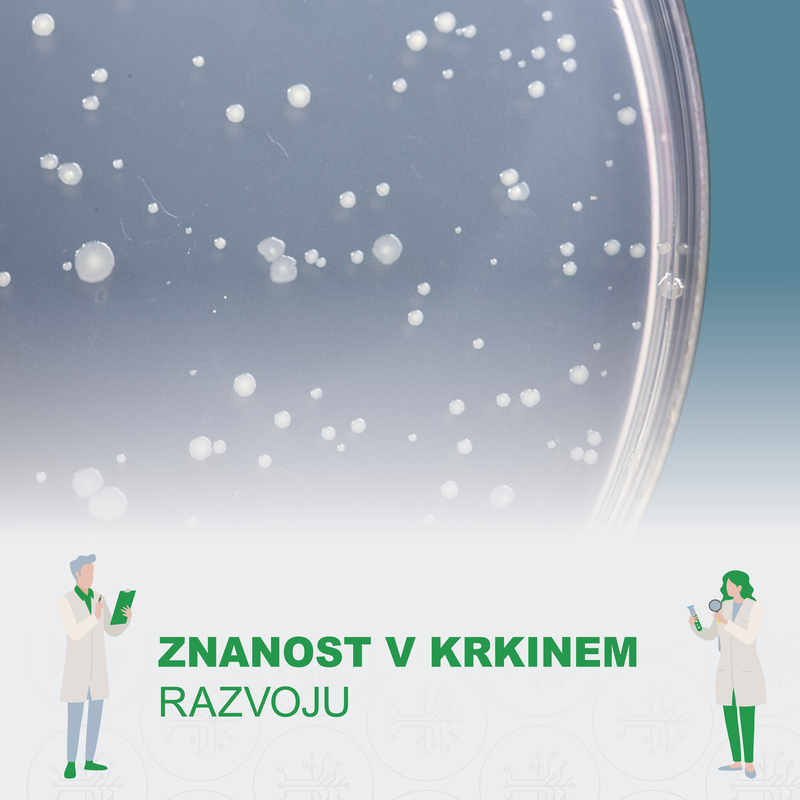

Novice

Mladi raziskovalci kot vir navdiha
Maks, Maj, Pia Olga, Eva in Matic, se razveselili 54. Krkine nagrade.

Le še nekaj dni za prijavo na razpis za 54. Krkine nagrade
Je na seznamu mladih avtorjev tudi tvoje ime? Če ne, je še vedno čas za oddajo raziskovalne naloge.

Raziskovalne naloge dijakov kažejo zavidljivo raven znanja
33 mladim raziskovalcem smo podelili 53. Krkine nagrade za srednješolske raziskovalne naloge.